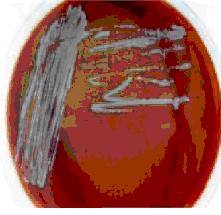
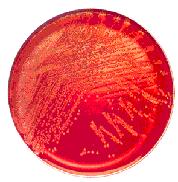
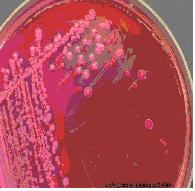
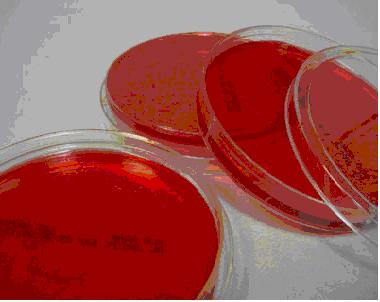
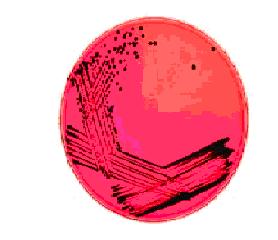
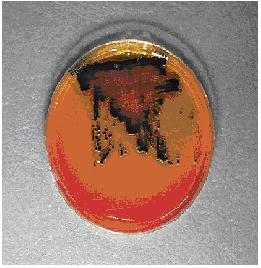
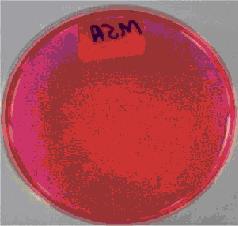
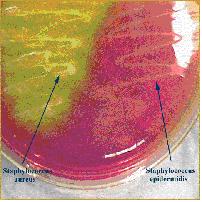
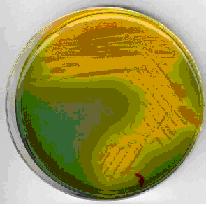
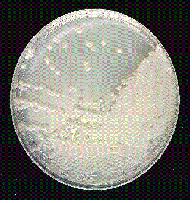

النبات

مواضيع عامة في علم النبات

الجذور - السيقان - الأوراق

النباتات الوعائية واللاوعائية

البذور (مغطاة البذور - عاريات البذور)

الطحالب

النباتات الطبية


الحيوان

مواضيع عامة في علم الحيوان

علم التشريح

التنوع الإحيائي

البايلوجيا الخلوية


الأحياء المجهرية

البكتيريا

الفطريات

الطفيليات

الفايروسات


علم الأمراض

الاورام

الامراض الوراثية

الامراض المناعية

الامراض المدارية

اضطرابات الدورة الدموية

مواضيع عامة في علم الامراض

الحشرات


التقانة الإحيائية

مواضيع عامة في التقانة الإحيائية


التقنية الحيوية المكروبية

التقنية الحيوية والميكروبات

الفعاليات الحيوية

وراثة الاحياء المجهرية

تصنيف الاحياء المجهرية

الاحياء المجهرية في الطبيعة

أيض الاجهاد

التقنية الحيوية والبيئة

التقنية الحيوية والطب

التقنية الحيوية والزراعة

التقنية الحيوية والصناعة

التقنية الحيوية والطاقة

البحار والطحالب الصغيرة

عزل البروتين

هندسة الجينات


التقنية الحياتية النانوية

مفاهيم التقنية الحيوية النانوية

التراكيب النانوية والمجاهر المستخدمة في رؤيتها

تصنيع وتخليق المواد النانوية

تطبيقات التقنية النانوية والحيوية النانوية

الرقائق والمتحسسات الحيوية

المصفوفات المجهرية وحاسوب الدنا

اللقاحات

البيئة والتلوث


علم الأجنة

اعضاء التكاثر وتشكل الاعراس

الاخصاب

التشطر

العصيبة وتشكل الجسيدات

تشكل اللواحق الجنينية

تكون المعيدة وظهور الطبقات الجنينية

مقدمة لعلم الاجنة


الأحياء الجزيئي

مواضيع عامة في الاحياء الجزيئي


علم وظائف الأعضاء


الغدد

مواضيع عامة في الغدد

الغدد الصم و هرموناتها

الجسم تحت السريري

الغدة النخامية

الغدة الكظرية

الغدة التناسلية

الغدة الدرقية والجار الدرقية

الغدة البنكرياسية

الغدة الصنوبرية

مواضيع عامة في علم وظائف الاعضاء

الخلية الحيوانية

الجهاز العصبي

أعضاء الحس

الجهاز العضلي

السوائل الجسمية

الجهاز الدوري والليمف

الجهاز التنفسي

الجهاز الهضمي

الجهاز البولي


المضادات الميكروبية

مواضيع عامة في المضادات الميكروبية

مضادات البكتيريا

مضادات الفطريات

مضادات الطفيليات

مضادات الفايروسات

علم الخلية

الوراثة

الأحياء العامة

المناعة

التحليلات المرضية

الكيمياء الحيوية

مواضيع متنوعة أخرى

الانزيمات
أنواع الأوساط الغذائية Media وخصائصها
المؤلف:
اعداد المرجع الالكتروني للمعلوماتية
المصدر:
almerja.com
الجزء والصفحة:
4-2-2016
221706
أنواع الأوساط الغذائية Media وخصائصها
1- Chocolate Agar
• بيئة غنية Enriched Media تنمو عليها أغلب البكتيريا
• تحتوي على عوامل X و V الناتجة من تفجر كريات الدم الحمراء RBCs والتي يمكن من خلالها نمو Heamophilus spp و Neisseriae والتي تعتبر هذه الأنواع من البكتيريا صعبة النمو Fastidious .

2- Blood Agar
• بيئة غنية Enriched Media تنمو عليها معظم البكتيريا
• بيئة تفريقية Differential بين أنواع البكتيريا المحللة للدم عن طريق التحلل الكامل للدم Beta hemolytic مثل Sterpt. Pyogenes و Sterpt. Agalactiae أو التحلل الجزئي للدم مثل Alpha hemolytic مثل Sterpt. Pneumonia و Sterpt. Viridans أو عدم التحلل للدم Non hemolytic مثل Sterpt. Faecalis و Sterpt. Bovis .

3- MacConkey Agar
• بيئة تفريقية للتفريق بين البكتيريا المخمرة للاكتوز Lactose fermenting والتي تأخذ اللون الأحمر مثل E.coli و Klebsiella و Enterobacter ، وبين البكتيريا الغير مخمرة للاكتوز Non-lactose fermenting والتي ليس لها لون (شفاف) مثل Proteus و Salmonella و Shigella .
• تحتوي على Crystal violet أو Bile Salts بحيث تسمح للبكتيريا السالبة لصبغة جرام بالنمو وتثبط نمو الموجبة لصبغة جرام

4- (ٍStine Lactose electrolyte deficient (CLED
• وسط لزراعة عينات الجهاز البولي .
• بيئة تفريقية للتفريق بين البكتيريا المخمرة للاكتوز Lactose fermenting والتي تأخذ اللون الأصفر مثل E.coli ، وبين البكتيريا الغير مخمرة للاكتوز Non-lactose fermenting والتي ليس لها لون (شفاف) مثلAcnitobacter بسبب وجود الكاشف Bromo-thymol blue .
• لها نفس وظيفة الـ MacConkey Agar


5- ( Xylose lysine deoxycholate (XLD
• بيئة اختيارية تفريقية لـ Salmonella و Shigella حيث أن الـ Salmonella تأخذ اللون الوردي لوجود Phenol Red مع وجود لون أسود في المركز نتيجة تحلل مواد موجودة في البيئة ينتج عنها غاز H2S والـ Shigella تأخذ مستعمراتها اللون الوردي فقط .

6- Salmonella Agar (S.S Agar) Shigella
• بيئة اختيارية لا تسمح بنمو البكتيريا الموجبة لصبغة جرام وبعض البكتيريا السالبة لصبغة جرام ماعدا Salmonella Shigella & بسبب وجود Na-citrate & bile salts
• بيئة تفريقية لـ Salmonella و Shigella حيث أن الـ Salmonella تأخذ لون البيئة (شفاف) مع وجود لون أسود في المركز نتيجة تحلل مواد موجودة في البيئة ينتج عنها غاز H2S والـ Shigella تأخذ مستعمراتها لون الوسط(شفاف) .

7- ( Mannitol salt Agar (MSA
• بيئة تفريقية للتفريق بين Staphylococcus species و Staphylococcus aureus التي تخمر المانيتول بتأثيرها على لون الكاشف Phenol Red وتعطي اللون الأصفر بينما الـ Staph. الأخرى لا تخمر المانيتول .
• بيئة اختيارية لأن تركيز الأملاح العالي (Nacl 7.5%) الموجود فيه يثبط نمو الميكروبات الأخرى .

8- Thiosulphate citrate bile salt Agar (TCBS)
• بيئة اختيارية لعزل الكوليرا Vibrio Cholerae
• تثبط نمو معظم الـ Enterbacteria والبكتيريا الموجبة لصبغة جرام بسبب احتوائها على مواد مثبطة وكذلك قلوية PH الوسط العالية.

9- Mueller Hinton Agar
• بيئة ضعيفة المواد الغذائية .
• مناسبة لعمل اختبارات الحساسية لأنها لا تحتوي على أية نسب من المواد الكيميائية بحيث لا تتفاعل مع المضادات الحيوية .

10- Bile Esculine
• بيئة تفريقية بين الأنواع المختلفة من الـ Streptococcus و الـ Enterococcus (Strept. Faecalis) التي تفرز عند نموها على هذه البيئة إنزيماً يفكك مادة الأسكولين فيتشكل مركب أسكولتين والذي يتحد مع أيونات الحديد الموجود بالبيئة على شكل سترات الحديد ويتكون مركب اسود يدل على وجود Enterococcus
• أيضاً وجود (4% أملاح الصفراء) يثبط الكثير من البكتيريا دون أن يؤثر على نمو Enterococcus .

11- (Sabouroud Dextrose Agar (SDA
• بيئة اختيارية لنمو الفطريات .
• الـ PH حامضي لذلك لا تسمح بنمو البكتيريا .
جدول يوضح العينات الطبية والأوساط المفضلة لزراعتها كما يُعمل به في كثير من المستشفيات


Sterilization of Media
*All media are sterilized by moist heat only; there is no dry heat sterilization (160c/2hours) or (170c/1.5 hour).
*The most common sterilization of media by autoclave (121c/15minute).
Autoclave is part of moist heat sterilization.
*Sterilization by inspissations (80c) for example: L J media.
*membrane filtration for thermolabile for example: Christian media for urease test.
*most of the selective media are sterilized by boiling -No autoclave
المزارع البكتيرية
مكونات المزارع البكتيريه وتحضيرها
تمثل الاوساط الزراعيه للبكتيريا العنصر الغذائي من متطلبات النمو ولذلك فان هناك انواعا كثيرة مختلفه من حيث المحتوى الغذائي بحيث يواجه متطلبات نمو انواع شتى من البكتيريا ,وتصنف الاوساط الزراعيه حسب قوامها الى صنفين هما:
الاوساط الصلبة (شبه الصلبة)
وهذه تشبه في شكلها وقوامها الجلي . وسبب صلابتها هو اضافته ماده الاجار اليها التي تقوم بتصليب الوسط ولا يتدخل في التغذيه ابدا ولذلك تسمى احيانا هذه الاوساط.
الاوساط السائله
وهذه الاساك قد تحتوي على نفس المواد الغذائيه في الوسك الصلب لكن بدون مادة تصليب.نصب النوع الاول في اطباق خاصه تسمى اطباق بتري ,بينما نصب الثانيه في انابيب زجاجيه او قناني لسهولة التداول.امامن ناحية المحتوي الكيماوي فان الاوساط تنقسم الى الاقسام التاليه:
1- الاوساط البسيطة الطبيعيه
وهذه تواجه متطلبات نمو البكتيريا ذاتية التغذية , وبعضها غير ذاتية التغذيه , وتحتوي مركبات غذائيه بسيظه.
2- الاوساط الغنية
وهذه الاوساط العادية البسيطه مضافا اليها مواد غذائيه غنية اضافية مثل الدم والمصل او مستخلصات النباتات او الحيوانات لمواجهة متطلبات نمو الجراثيم صعبة الارضاء.
3- الاوساط الاختياريه
اضافة مواد كيماوية معينة بتركيز معين يؤدي الى السماح لنمو مجموعة من البكتيريا ,ومنع نمو مجموعة اخرى مثل اضافة صبغة جرام ,بتركيز محدد مثال ذلك:
الاوساط المفرقة
الوسطالذي يسمح لنمو نوعين من البكتيريا بحيث يستطيع المشاهد ان يميز بينهما لظهورهما بصفات مختلفة,مثل اضافة الدم الى الوسط الزراعي يؤدي الى التمييز بين البكتيريا المحلله من البكتيريا غير المحللة له ,حيث تظهر حلقة فارغة من الدم حول المستعمرة اذا كانت الخلية البكتيريه من النوع المحلل للدم بينما لاتظهر حلقة شفافة حول المستعمرة في حالى ما تكون البكتيريا غير المحللة للدم وبذلك تلعب الاوساط المحتوية على الدم دور الوسط الغني والمفرق في نفس الوقت.
هذه هي الانواع الرئيسيه الاهم, رغم ذلك يوجد انواع اخرى خاصة لخدمة باحث معين , ونوع لعدالخلاياالخلايا البكتيريه و(اخرى) لتشخيص صفات بكتيريا معينه.
تحضير الاوساط الزراعية
يمكن تحضير المزارع الجرثومية باتباع الخطوات التالية:
1- زن مسحوق الوسط الجاهز الجاف وحسب التعليمات المثبته على علبه الوسط.
2- اذبها في حجم الماء المقطر المحدد في التعليمات , وغالبا ما يكون لتر وتتم الاذابة اما بالتحريك او قد يحتاج اللى التسخين.
3- وزع المحلول (الوسط)في انابيب اختبار وغطها .
4- ضع الانابيب او القارورة (اذا كان الوسط صلبا)في جهاز التعقيم بالبخار لدة15دقيقة تحت ضغط 15باوند|انش, ودرجة الحرارة 121م لهدف التعقيم.
5- اخرجها من الجهاز وانتظر حتى تبرد قليلا وصبها في اطباق معقمه من اطباق بتري في جو خال من تيار هوائي على طاولة نظيفه مظهرة ومحاطة بلهب بنسون مشتعل,وتبقى الاطباق مفتوحة حتى لايتكثف البخار على غطاء الطبق بعد التجميد تحفظ في الثلاجة اذا كان الوسط سائلا فلا داعي للصب وتخرج الانابيب من جهاز التعقيم, وينتظر حتى تبرد ثم تحفظ في الثلاجة لحين الاستخدام.
الاكثر قراءة في البكتيريا
اخر الاخبار
اخبار العتبة العباسية المقدسة
الآخبار الصحية

قسم الشؤون الفكرية يصدر كتاباً يوثق تاريخ السدانة في العتبة العباسية المقدسة
"المهمة".. إصدار قصصي يوثّق القصص الفائزة في مسابقة فتوى الدفاع المقدسة للقصة القصيرة
(نوافذ).. إصدار أدبي يوثق القصص الفائزة في مسابقة الإمام العسكري (عليه السلام)